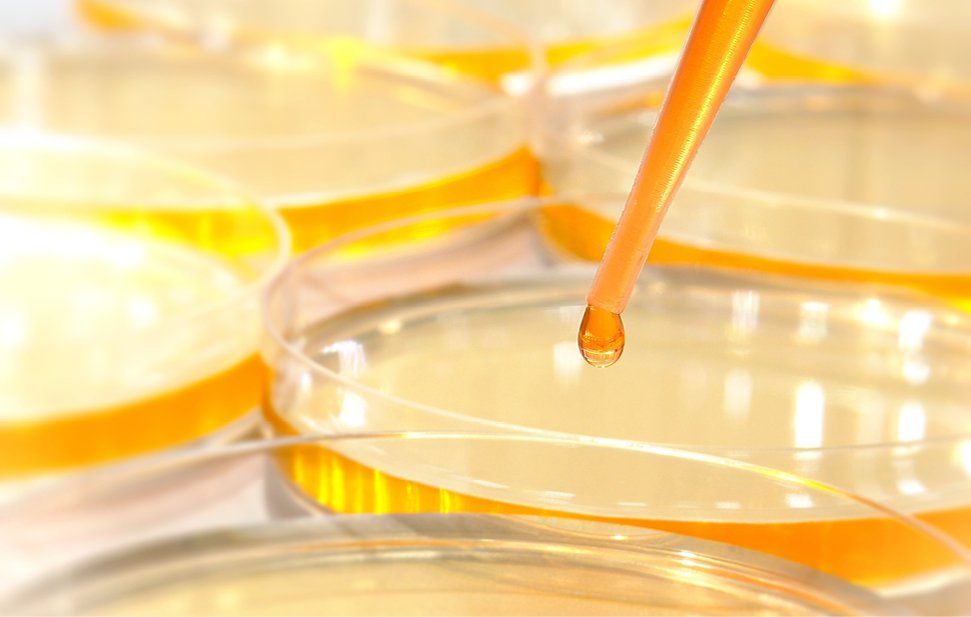

EACH TABLET CONTAINS
- 6 billion live & active beneficial bacteria from the following species:
- Lactobacillus acidophilus
- Lactobacillus salivarius
- Lactobacillus bulgaricus
- Bifidobacterium bifidum
- Streptococcus thermophilus
RECOMMENDED DOSAGE
For Adults: 1 capsule, once to twice daily, after meals
AVAILABLE IN
60 capsules
REGISTRATION NO : MAL07050245XC
This is supplement product advertisement (KKLIU 0110/2020)
WHAT IS SPECIAL ABOUT THIS PRODUCT?
- Produced using a freeze-dried (lyophilisation) technique for better viability of good bacteria.
- Cultured using tropical strains that are more robust and Probio-5 does not require refrigeration if stored in cool, dry places away from sunlight.
- Cultured in a base of supernatant yoghurt concentrate that provides food for the viability of bacteria. The supernatant also acts a buffer for bacteria to survive gastric acid as it passes through the stomach, enabling the bacteria to better colonise the gut.
- Packed in amber glass bottles in dehumidified conditions to prolong the viability of bacteria
WHO SHOULD USE THIS PRODUCT?
- Those keen to maintain good gastrointestinal and digestive health.
- Seniors with weaker digestive systems.
- Frequent travelers will also benefit from this product.
- Probio-5 is suitable for vegetarians.